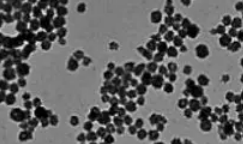

过氧化钙纳米颗粒(nano-CaO₂)是一种兼具供氧、氧化及生物安全性的功能纳米材料,在多个领域应用前景广阔。
核心特性
- 缓慢释氧与释活性氧:在水或酸性环境中逐步分解,释放氧气和过氧化氢。过氧化氢进一步转化为活性氧,兼具供氧和温和氧化双重作用。
- 物理化学稳定性:固态下稳定性强,不易自燃或爆炸,储存和使用安全性较高。在潮湿环境中才会缓慢反应,可控性好。
- 生物相容性:降解产物为钙离子和氧气,钙离子可参与生物体内代谢,无明显毒性残留,生物安全性优于多数化学氧化剂。
制备方法
- 反相微乳液法:以油相为分散介质,通过表面活性剂形成微反应器,控制 CaO₂颗粒的成核与生长,可制备粒径均一(10-100nm)的纳米颗粒。
- 沉淀法:在水溶液中通过钙盐与过氧化物反应生成 CaO₂,加入分散剂抑制颗粒团聚。
- 溶胶 - 凝胶法:通过前驱体水解、缩合形成凝胶,经干燥、焙烧得到纳米 CaO₂,产物纯度高、分散性好。
注意事项
- 具有一定氧化性,高浓度下可能对细胞或生物体造成氧化损伤,应用时需控制剂量和释放速率。
- 纳米颗粒易团聚,实际应用中需通过表面修饰(如包覆聚合物、改性剂)提升分散性和稳定性。
温馨提示:仅用于科研,不能用于人体!
相关产品:
透明质酸纳米颗粒
白蛋白纳米颗粒
硒化铁纳米棒
硒纳米颗粒
中空介孔碳纳米球
碳纳米球
过氧化钙纳米颗粒
超小尺寸铜纳米粒子
中空介孔硫化铜纳米颗粒
硫化铜纳米颗粒
壳聚糖硫化铜纳米颗粒
392

被折叠的 条评论
为什么被折叠?



